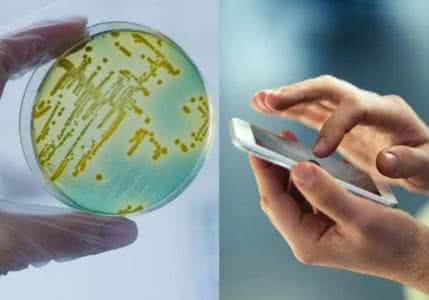
抗真菌细菌转基因植物 电子产品携带细菌量如此惊人 如何抗菌

现在,智能手机几乎人手一部,手机上除了有你的照片、音乐、联系人等,还有大量的大肠杆菌。研究发现,手机上每平方英寸的细菌数量可能达到25107个,令人咋舌,是卫生间马桶盖的十几倍。被细菌污染的还有电脑键盘,每平方英寸有3000个细菌,电脑鼠标有1600个。
爱玩游戏的朋友们也要注意了,游戏手柄的带菌量也高得惊人,其中大肠杆菌是潜伏的侵入者之一。还有平板电脑、电子阅读器,也是很多人爱不释手的电子产品,在公交车上、饭桌上,总不乏有人捧在手里,甚至去卫生间时也要如影随形,时刻不离手。殊不知,有人对一部iPad进行测菌试验,发现了600个金黄色葡萄球菌。
如何避免大量细菌侵入人体呢?首先要避免细菌大量堆积,经常用酒精棉球或专业清洁剂擦拭,保持这些手持电子设备干净清洁。
使用手持电子设备前后要洗手,尽量不在卫生间或公共场所把玩,杜绝吸附上大肠杆菌。
以上是用户分享关于电子产品携带细菌量如此惊人 如何抗菌的资料希望对您有所帮助了,感谢您对爱华网的支持! 爱华网
爱华网



